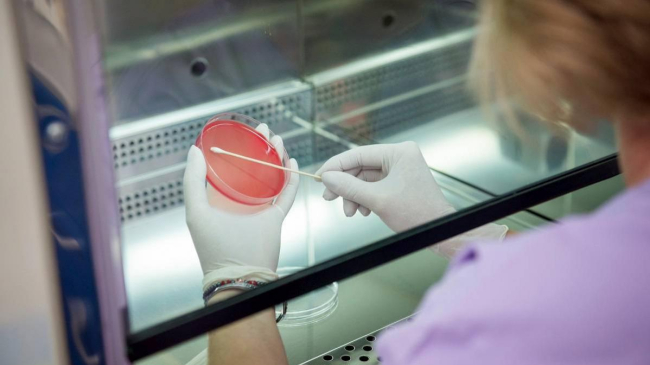
mamaplus

Tarifele pentru hemodializă, hemodiafiltrare și investigaţia citopatologică (Pap-test convenţional), vor fi reduse, ceea ce va spori accesul pacienților la servicii medicale, prin posibilitatea contractării de către Compania Naţională de Asigurări în Medicină a unui număr mai mare de servicii medicale.
Astfel, tarifele pentru hemodializă, se vor reduce de la 2395 lei - la 1995 lei, pentru hemodiafiltrare, de la 2645 lei - la 2195 lei, iar pentru investigaţia citopatologică, de la 125 lei - la 62 lei, ceea ce va permite contractarea suplimentară a 16 000 ședințe de hemodializă, 2100 ședințe de hemodiafiltrare și 50 800 investigaţii, prestate în cadrul screeningului cancerului de col uterin.
În acest sens, astăzi a fost aprobat proiectul de Hotărâre de Guvern privind modificarea Anexei nr. 3 a HG nr. 1020/2011 „Cu privire la tarifele pentru serviciile medico-sanitare”.
Proiectul mai prevede includerea tarifelor pentru serviciile medicale noi, cum ar fi determinarea calitativă a ARN virusului SARS-CoV-2 prin metoda PCR în regim Real Time și determinarea anticorpilor anti-SARS-CoV-2 IgM, IgG prin metoda Elisa, care va permite CNAM să contracteze și să achite serviciile medicale de laborator pentru diagnosticul infecției Covid-19.
Serviciile medico-sanitare incluse în proiectul dat sunt prestate de instituțiile medicale încadrate în sistemul asigurării obligatorii de asistență medicală și finanțate din fondurile asigurării obligatorii de asistență medicală.